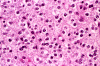
Com401-2-Perm10.gif (127501 bytes)

Jones stain
Jones stain
| A 5 year-old Boy with
Nausea and Vomiting for Three Months. January, 2004, Case 401-2. Home Page |
These photos were obtained from the formalin fixed paraffin embedded sections.
 |
 |
 |
 |
 |
 |
| I. | J | K. | L. | M. | N. |
 |
 |
|
 |
 |
 |
| O. | P. | Q. | R. |
S. Jones stain |
T. Jones stain |